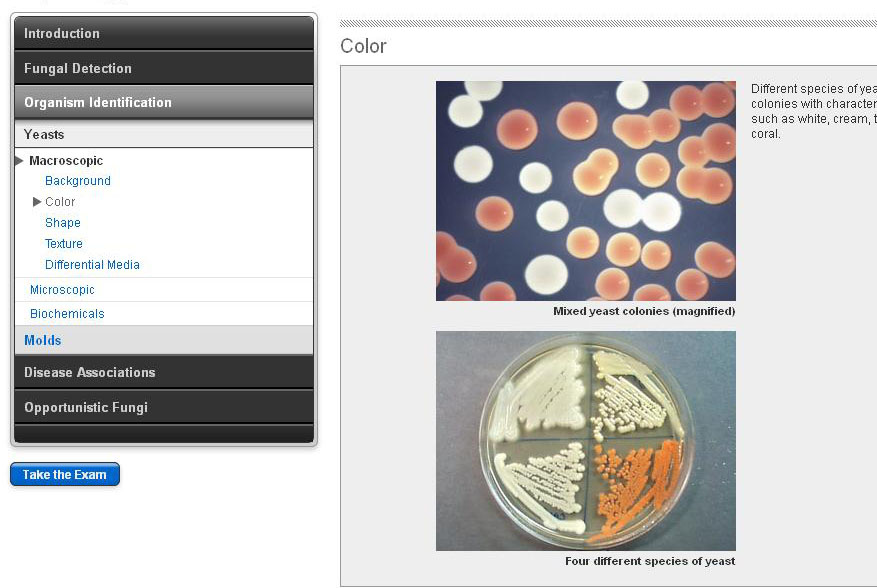

Mycology
Instructor:
Marie B. Coyle, PhD; Dave Nowowiejski, MS, MT(ASCP); Karen LaFe, MT(ASCP); Deborah Ritter, MS, CLS(NCA); Janet D. Curtis, BS, MT(ASCP); Adam R. Orkand, BA; Michael L. Astion, MD, PhD
Contact Hours:
2.0
Date:
January 01, 2025 - December 31, 2026
Description:
Isolation and identification of yeast and molds from clinical specimens, for physicians, microbiology staff and students.
Learning Objectives:
- Name the four classes of fungi responsible for human infections.
- List three direct techniques used in medical mycology.
- Describe the unique morphologic features that define different molds.
- Define opportunistic fungi and list two common opportunists.